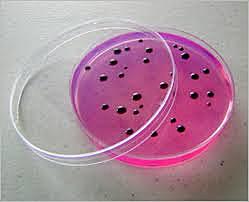
Richard Petri (Microbiólogo Alemán)

-
Escribe el libro de Contagione et contagiosis morbis et curatione, donde habla sobre la lepra, la peste y la sífilis, eran trasmitidas por partículas imperceptibles al ojo humano, llamadas seminaria contagiorum
-
Descubrió el principio óptico del microscopio
-
Descubrió el funcionamiento del sistema circulatorio, resumió la opinión de los detractores de la doctrina en la generación espontanea con el aforismo omnia ex ovo
-
en el libro titulado Micrographia, Robert Hooke acuñó el término célula.
la célula como unidad estructural y funcional de nuestro cuerpo, como asiento de las lesiones y por tanto de la enfermedad y como agente terapéutico en la nueva medicina re generativa. -
Adoptó por primera vez en la historia una posición contraria a la teoría de la generación espontánea, aceptada desde tiempos de Aristóteles. La afirmación según la cual de la carne en putrefacción nacen larvas de dípteros
-
Conocido como el padre de la microbiología, autentico el descubrimiento de la existencia del mundo visible,construyo mas de 500 microscopios, identificando los seres pequeños como animalculos.
-
Demostró que no existe la generación espontánea de la vida, abriendo camino a Pasteur, tras rechazar la teoría de la generación espontánea
-
Fundador de la microbiología y pionero de la medicina moderna, quien demostró que los organismos aparecían transportados por el aire y que no surgían espontáneamente.
-
Sus investigaciones y descubrimientos preliminares sobre el ADN, aíslo varias moléculas con riqueza de fosfatos y a partir del núcleo de los glóbulos blancos identificó a las nucleinas, que hoy llamamos ácidos nucleicos
-
Contribuyó con Louis Pasteur y John Tyndall a desterrar la generación espontánea, según la cual los organismos vivos eran capaces de desarrollarse a partir de la materia inorgánica, ademas publico la formula de un medio de un cultivo similar, al que se pueden añadir diversos azucares
-
Se le considera, el padre de la bacteriología, y el que sentó las bases de la microbiología médica moderna. Descubrió la bacteria productora del ántrax o carbunco y la bacteria productora de la tuberculosis.
-
Realizo avances fundamentales en el diseño de microscopios y en la óptica teórica, incremento el poder de la resolución de los microscopios
-
Inventó las denominadas placas de Petri en la microbiología utilizados para albergar los medios de cultivo utilizados en bacteriología.
-
Extrajeron varias moléculas de las bacterias muertas Para averiguar cuál era la más importante para la transformación.
-
con su trabajo con los agentes causales de la difteria (Corynebacterium diphteriae) y el tétano (Closfridium tetani), idearon el método para producir inmunidad contra las infecciones causadas por estos organismos. mediante la inyección de sus toxinas (antígenos) en animale.
-
demostraron que una sustancia extraída de las células de levadura podía producir fermentación alcohólica fuera de la célula viva. A esta sustancia se le denominó "enzima"de la palabra griega zyme que significa levadura o fermento.
-
Descubren el treponema pallidum culpable de la sífilis
-
publicó acerca de la acción anti bacteriana de cultivos de la especie fungosa Penicillium notatum la cual mataba a la bacteria Staphylococcus aureus cuando el hongo contaminaba accidentalmente las placas de cultivo
-
Fue la primera estructura en ser observada en setalle por ser cristalizado
-
Laboratorios Siemens y Halske de Berlín lanzaron el primer modelo comercial de este microscopio creado por Ernest Ruska
-
Ellos demostraron que los bacteriófagos logran reproducirse mediante la inyección de su ADN en las células bacterianas, dejando la mayor parte de su proteína en el exterior. Estos resultados evidenciaron toda la importancia del ADN en la multiplicación de los bacteriófagos y, para muchos fue el experimento decisivo para concluir que éste era el material genético.
-
propusieron la estructura de la doble espiral para el ADN; esto permitió aclarar la forma en que la información genética es almacenada y expresada.
-
encontraron que éste funciona como un pequeño «código genético»; propusieron la teoría del Operón, la cual explicó cómo la información genética controla la síntesis de proteínas
-
Es el inventor de la Prueba Ames, un sistema de bajo costo para probar la mutagenicidad de los compuestos.
-
se desató en el sur de Sudán, a 800 kilómetros del monte Elgón,
una epidemia que cobró centenares de víctimas. Esta epidemia comenzó con un empleado de una fábrica procesadora de algodón en la aldea de Nzara, el cual murió a consecuencia de una fuerte hemorragia interna, contagiando a otros tres compañeros que también fallecieron. La causa fue atribuida a un filovirus asociado con el virus Marburgo y se llamó Ebola Sudán -
Demostró que las arqueobacterias presentan una línea evolutiva diferente a las bacterias (secuencia del ARN mitocondrial 16s)
-
Declara la erradicación de la viruela, es la primera enfermedad combatida a escala mundial.
-
Se han detectado casos esporádicos de infección en seres humanos por el virus H5N1 de origen asiático en otros países, principalmente en Asia y África.
-
El microorganismo productor de la enfermedad de los legionarios, el genoma del saccharopolyspora erythraea el microorganismo productor del antibiótico eritromicina,
-
La gripe porcina es una infección causada por un virus. Se llama así por un virus que los cerdos contraen. La gente, generalmente, no contrae esta gripe pero pueden darse infecciones. En 2009, una cepa de gripe porcina llamada H1N1 infectó a varias personas alrededor del mundo, la OMS declaró la pandemia en junio de 2009,
Plan projects on a visual timeline
Map milestones, phases, deadlines, and key events in one place so the sequence is easier to see and share. Timetoast is a timeline maker for work, school, research, and stories.